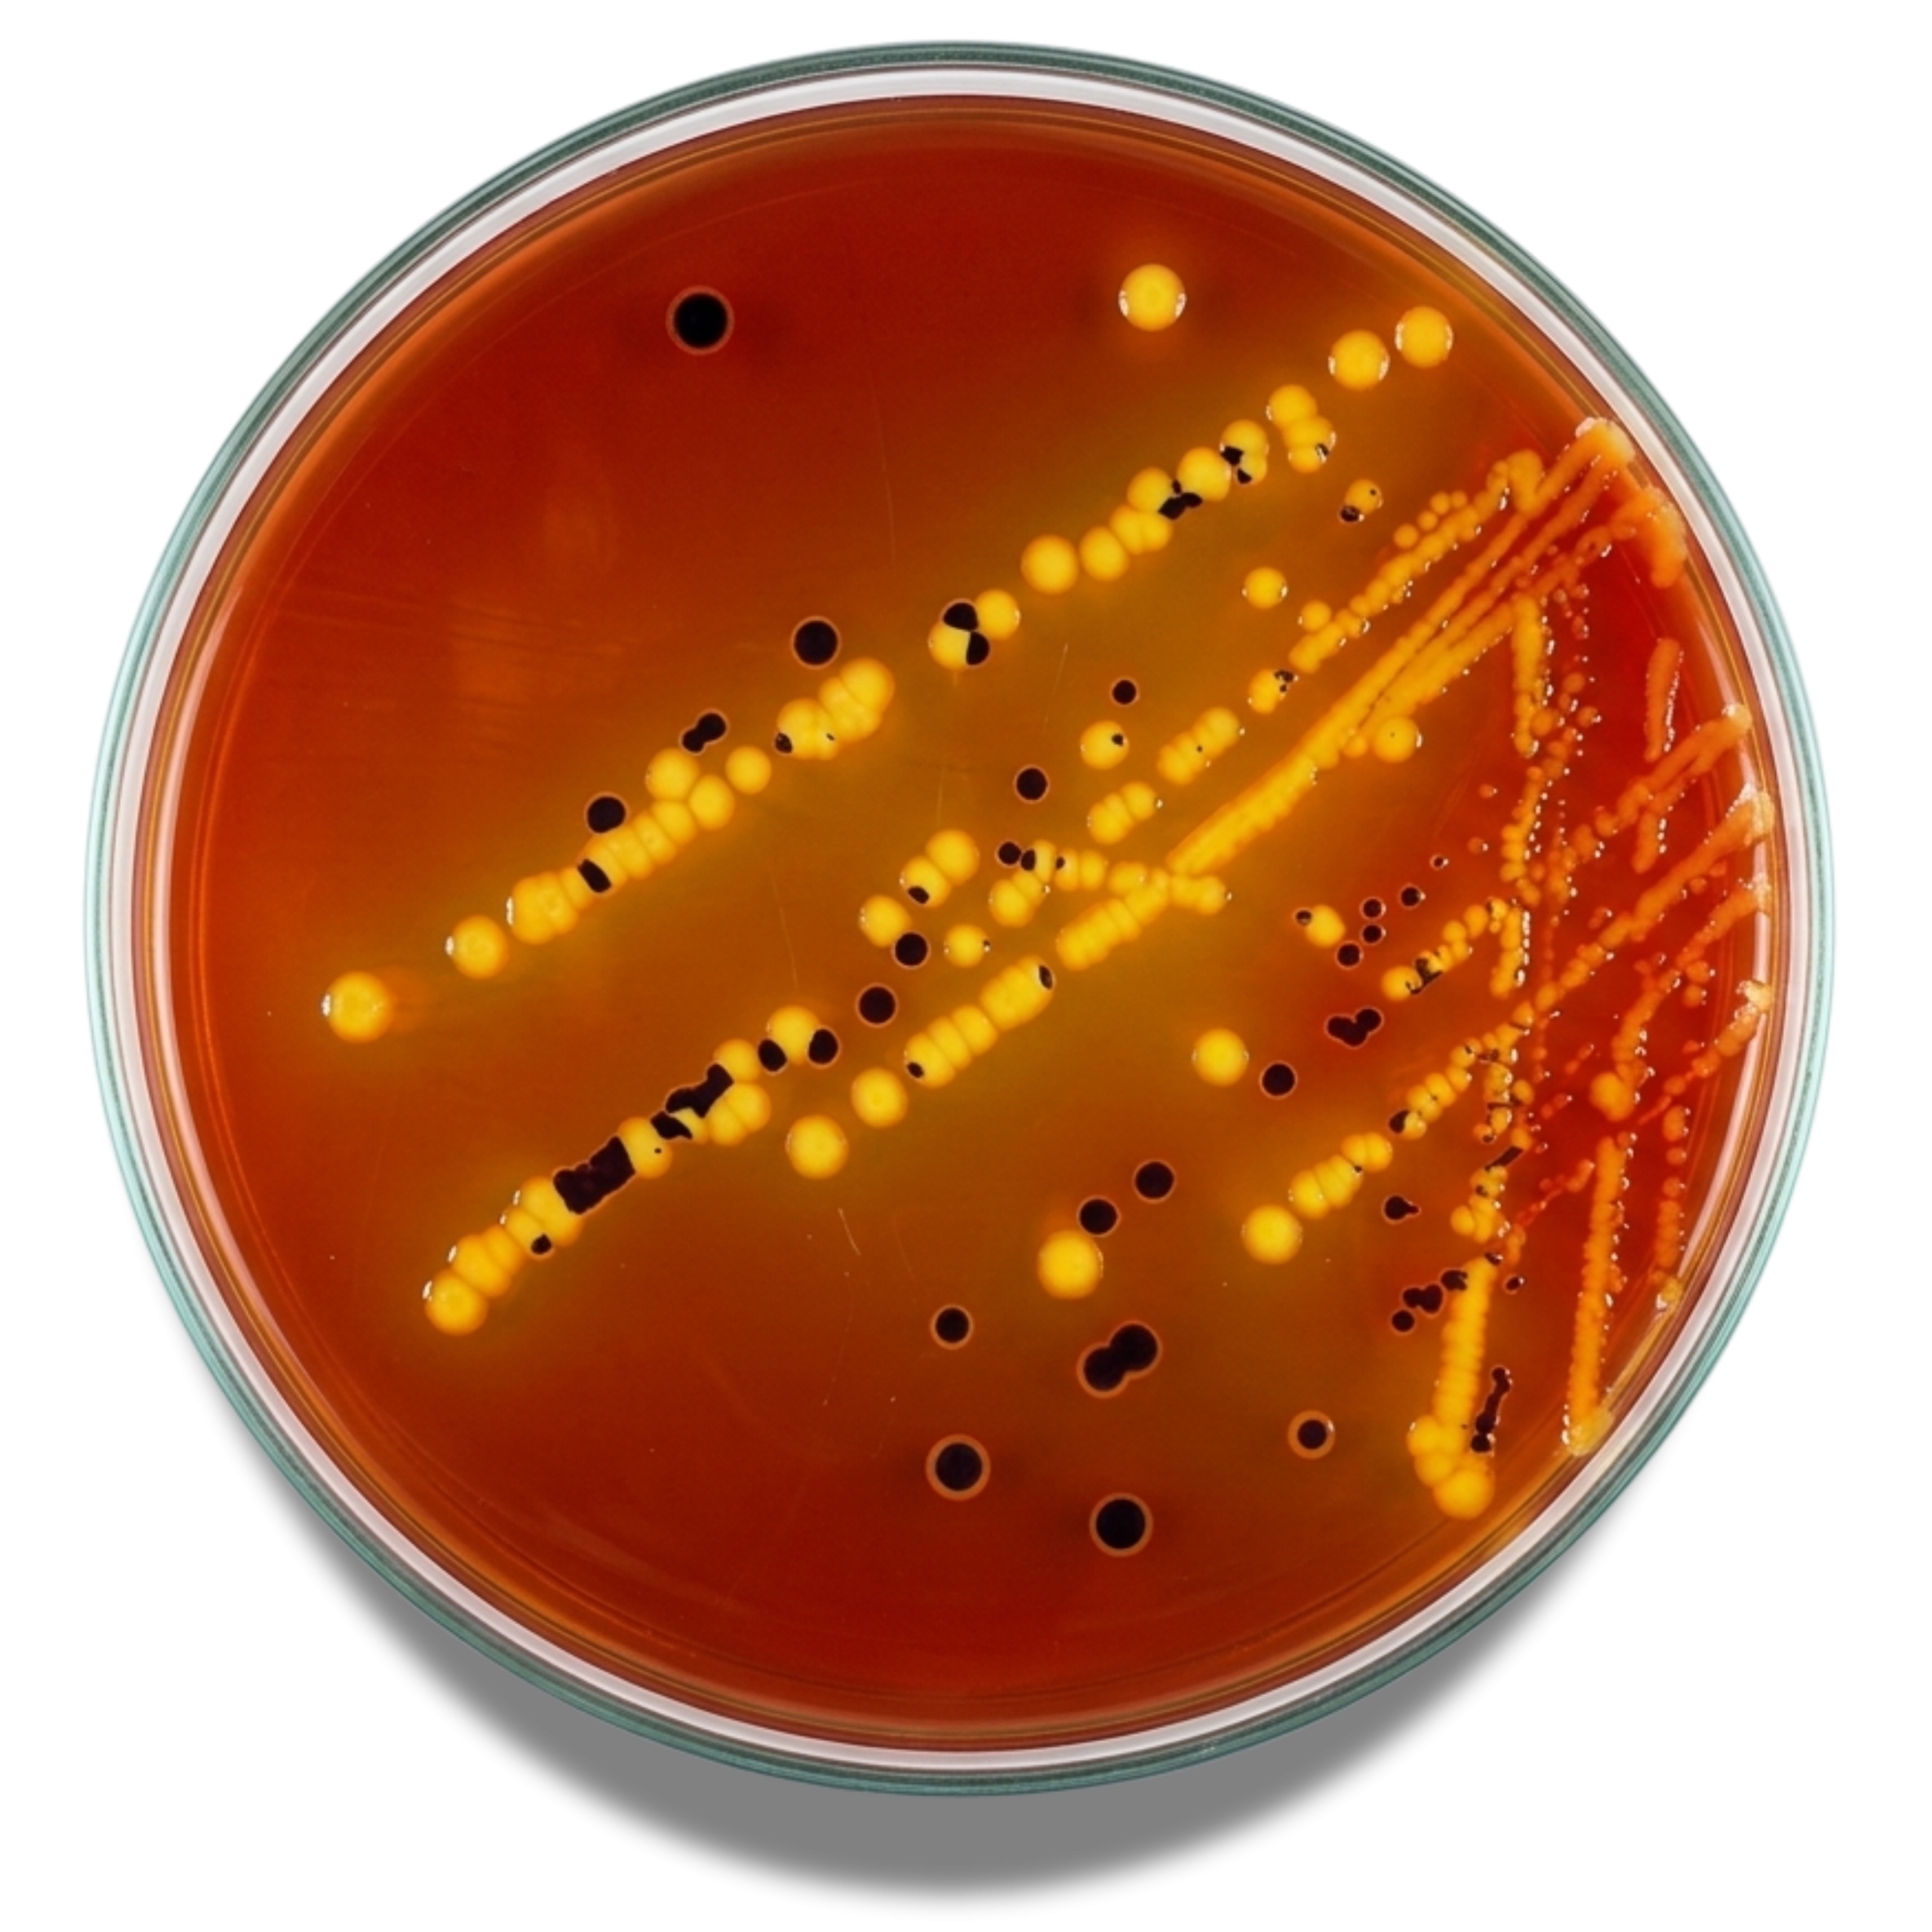

- Wishlist
- SKU : 4022062
- 500 g
Additional Info
| Brand |
BioLife |
|---|---|
| Unit |
500 Grams |
In vitro diagnostic. Selective and differential medium for the isolation of Gramnegative enteric pathogens, especially Salmonella and Shigella, from clinical and non-clinical specimens.
Be the first to review “XLD AGAR” Cancel reply
You must be logged in to post a review.

Reviews
There are no reviews yet.